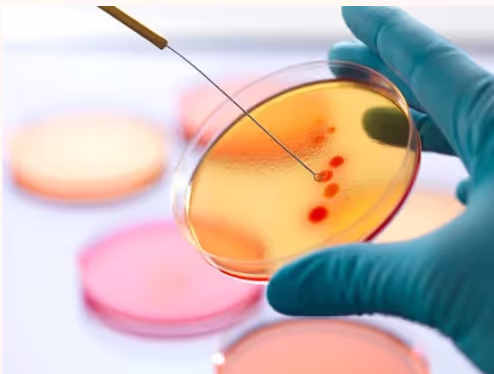

Built for food innovators
Smarter shelf-life decisions.
In minutes.
Accelerate food product development: predict shelf-life of food products, simulate microbial growth, and perfect recipes before physical testing

Shelf-life insights
in three simple steps

Input your product details
Select ingredients, storage conditions & packaging

Run expert simulation
Predict microbial growth & shelf stability before lab testing

Optimise & save time
Adjust parameters & maximize shelf-life efficiency
Better insights,
faster decisions
Faster results
Run simulations before committing to lab tests.
Cost-effective
Reduce unnecessary testing costs & accelerate R&D.
Science-backed
Built on validated microbiological data & expert models.
Who Can Benefit?
Our services are perfect for food producers, product developers, and quality assurance teams seeking to enhance their product’s shelf-life. Whether you’re developing innovative food products, working on sustainable packaging, or addressing spoilage concerns, our precision solutions provide the support you need to optimise your processes and make informed decisions.

More than software,
full-service shelf-life support
Shelfion isn’t just about shelf-life simulations. Our lab kits, laboratory services, and expert guidance help you fully control and optimize your product's microbial shelf-life.
Test Kits
Available for multiple food groups.
Fitted to your product and needs.
Less analyses, better confidence.
Laboratory
From spoilage organisms to pathogens.
Bacteria, yeast and mycology.
Challenge tests and tailored experiments.
Consultancy
Expert insights in food spoilage & food safety.
Master food shelf-life and food preservation.
Trusted & supported by
Our investment in this team underscores the belief in the market opportunity of their innovation. Next to the strong technology and the extended science on which the company is built, we were convinced by the exceptional drive and customer focus of the founding team. We are eager to support their continued success!

Innovative tools for diverse food products & ingredients
Our dedicated team of specialists is ready to support you with your shelf-life challenges. Offering tailored solutions for an unlimited variety of processed products.
Ready to take the
next step?
Get started with Shelfion today and bring efficiency to your new product developments

